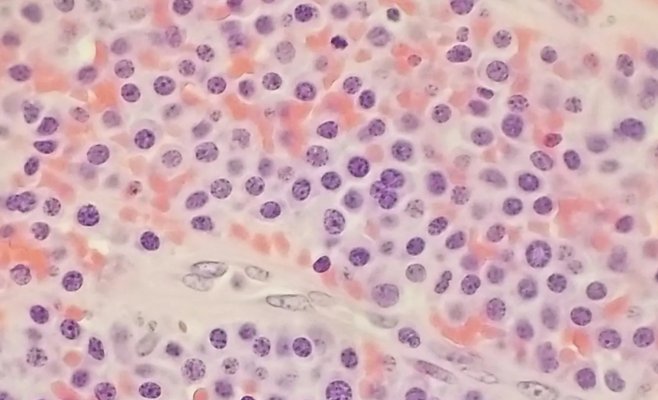
Казалось, будто что-то пожирает ее изнутри. Это была мультимиелома

Популярное
После возвращения учеников в школы вероятен рост числа новых случаев Сovid-19. С
начала года инфекция стала чаще встречаться у детей, посещающих детские сады и начальные школы. Одной из причин может быть распространение мутации британского коронавируса. Если бы были открыты средние школы, заболеваемость в них, вероятно, была бы даже выше, чем среди детей младшего возраста.
Об этом в среду на заседании школьного комитета сообщил директор Института медицинской информации и статистики (IHIS) Ладислав Душек. По его словам, нынешняя эпидемическая ситуация не дает оснований для корректировки текущих мер.
В связи с эпидемией сейчас открыты только детские сады и специальные школы, а также первые и вторые классы начальных школ, остальные обучаются дистанционно. По мнению правительства, другие ученики должны постепенно возвращаться в школы с 1 марта. Это будет зависеть от обеспечения тестирования на Covid-19.
Душек отметил, что эпидемия сейчас развивается «ужасно плохо». «К сожалению, в ближайшие недели, вероятно, не будет много возможностей для экспериментов», - сказал он.
Распространение заболевания у детей от 6 до 10 лет.
По словам Душека, с начала января болезнь все больше распространяется среди детей в возрасте от 6 до 10 лет. По его словам, это относительно небольшие вспышки, в среднем около шести человек в детских садах и школах, но это показывает, что эпидемическая ситуация ухудшается, вероятно, также в связи с новыми мутациями.
Глава IHIS напомнил, что в последние месяцы после любого ослабления мер число случаев коронавирусной инфекции среди подростков увеличивается. По его словам, если сейчас начнут работать все школы, можно предположить, что болезнь снова начнет распространяться.
По его словам, согласно международным исследованиям, закрытие школ само по себе не останавливает эпидемию, а школы не являются основным источником распространения болезни, но могут способствовать ее распространению. Это показывают исследования, например, из Австрии и Израиля. Австрийские ученые после открытия школ зафиксировали увеличение заболеваемости детей и учителей в 2,3 раза.
По словам Душека, самый высокий уровень заболеваемости среди детей младшего возраста сейчас наблюдается в регионах Градец-Кралове и Карловы Вары, где из-за критической ситуации закрыты районы Хеб, Соколов и Трутнов.
Министр здравоохранения Ян Блатны заявил в среду, что с 1 марта невозможно будет принимать дополнительных учеников в школы в этих районах, и нельзя исключать закрытие других регионов. Душек заявил, что ситуация значительно ухудшается также в Пардубицком и Пльзеньском регионах. Он назвал развитие эпидемии там предупредительным сигналом.
По словам Душека, всего с начала вспышки инфекции заразились около 37 тыс. учителей. Всего с марта прошлого года в Чехии подтверждено более 1,1 млн случаев заражения. По словам Ладислава Душека реальное число инфицированных, вероятно, в 2,5-3 раза выше.
.jpg)